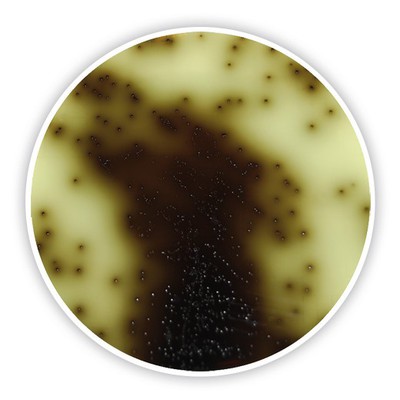
CP62 CP62

एस्कुलिन का उपयोग किस लिए किया जाता है?
एस्कुलिन पाउडरहॉर्स चेस्टनट पेड़ की छाल में पाया जाने वाला एक प्राकृतिक यौगिक है। इसका उपयोग आमतौर पर इसके पुनर्स्थापनात्मक गुणों के लिए किया जाता है। इसे आमतौर पर शमन करने वाले, ज्वरनाशक (बुखार कम करने वाले) और दर्द निवारक (पीड़ा कम करने वाले) विशेषज्ञ के रूप में उपयोग किया जाता है। आधुनिक चिकित्सा में, इसका उपयोग मुख्य रूप से इसके वासोप्रोटेक्टिव प्रभावों के लिए किया जाता है। यह मूल रूप से अपने शांत करने वाले और कोशिका सुदृढ़ीकरण प्रभावों के लिए जाना जाता है। इसका उपयोग सामान्य चिकित्सा में विभिन्न स्थितियों के इलाज के लिए किया जाता है, उदाहरण के लिए, त्वचा संबंधी समस्याएं, जोड़ों में दर्द और संचार संबंधी समस्याएं। यह कई मामलों में त्वचा देखभाल उत्पादों और त्वचा क्रीम में फिक्सिंग के रूप में पाया जाता है क्योंकि इसकी रक्त प्रवाह को और विकसित करने और वैरिकाज़ नसों की उपस्थिति को कम करने की क्षमता होती है। इसका उपयोग ठोस शिरापरक क्षमता में सहायता के लिए प्राकृतिक उपचारों में फिक्सिंग के रूप में भी किया जाता है।

इसी तरह, इसके घातक विकास गुणों के संभावित दुश्मन और यूवी विकिरण से बचाव की क्षमता के लिए भी इसका अतिरिक्त अध्ययन किया गया है। इसके बावजूद, यह ध्यान रखना आवश्यक है कि इन उद्देश्यों का समर्थन करने वाले तार्किक प्रमाण सीमित हैं, और आगे की जांच से एस्कुलिन के संभावित लाभों और स्वास्थ्य प्रोफ़ाइल को अधिक आसानी से समझने की उम्मीद है। किसी भी प्राकृतिक या वैकल्पिक इलाज का उपयोग करने से पहले चिकित्सा देखभाल विशेषज्ञ से बात करना भरोसेमंद रूप से विवेकपूर्ण है।
सीओए
|
विश्लेषण |
विनिर्देश |
परिणाम |
|
आभास |
सफेद पाउडर |
अनुरूप है |
|
गंध |
विशेषता |
अनुरूप है |
|
परख |
98 से बड़ा या उसके बराबर |
99.15 प्रतिशत |
|
कण आकार |
100 प्रतिशत पास 80 जाल |
अनुरूप है |
|
राख |
5.0 प्रतिशत से कम या उसके बराबर |
3.54 प्रतिशत |
|
सूखने पर नुकसान |
5.0 प्रतिशत से कम या उसके बराबर |
2.55 प्रतिशत |
|
हैवी मेटल्स |
10 पीपीएम से कम या उसके बराबर |
अनुरूप है |
|
जैसा |
2ppm से कम या उसके बराबर |
अनुरूप है |
|
पंजाब |
2ppm से कम या उसके बराबर |
अनुरूप है |
|
एचजी |
0.1पीपीएम से कम या उसके बराबर |
अनुरूप है |
|
सीडी |
1ppm से कम या उसके बराबर |
अनुरूप है |
|
जीवाणुतत्व-संबंधी |
||
|
कुल प्लेट गिनती |
1000cfu/g से कम या उसके बराबर |
अनुरूप है |
|
ख़मीर और फफूंदी |
100cfu/g से कम या उसके बराबर |
अनुरूप है |
|
साल्मोनेला |
नकारात्मक |
नकारात्मक |
|
ई कोलाई |
नकारात्मक |
नकारात्मक |
|
स्टैफ़्लोकोकस ऑरियस |
नकारात्मक |
नकारात्मक |
|
निष्कर्ष |
एंटरप्राइज़ मानक के अनुरूप |
|
एस्कुलिन कहां से खरीदें
शीआन सोनवु बायोटेक कंपनी लिमिटेड के पास वैश्विक व्यापार और स्वास्थ्य उद्योग में समृद्ध अनुभव है। विश्वास-आधारित और गुणवत्ता पर पहले जोर देना हमारी कंपनी का सिद्धांत है। हम उत्पाद की गुणवत्ता को सख्ती से नियंत्रित करते हैं, जिसका अर्थ है कि चयन कच्चे माल से शुरू होता है। इसके अलावा, हम हर विवरण को संभालते हैं और लागत को अधिकतम सीमा तक कम करते हैं, और फिर हमारे ग्राहकों को लागत प्रभावी उत्पाद मिल सकते हैं। इनके आधार पर ग्राहकों ने हमारे उत्पादों को काफी अच्छी प्रतिक्रिया दी है।' इसलिए जब आप शुद्ध एस्कुलिन पाउडर खरीदना चाहें तो आप शीआन सोनवु बायोटेक कंपनी लिमिटेड की तलाश कर सकते हैं।
शीआन सोनवु उत्पाद की गुणवत्ता को पूरी तरह से सुनिश्चित करता है, इसलिए नमूनों की आपूर्ति की जा सकती है। यहाँ मात्रा है.
|
रूप |
नमूना राशि |
न्यूनतम मात्रा |
|
पाउडर |
50g |
100g |
ग्राहकों की अच्छी टिप्पणी

एस्कुलिन एगर कैसे काम करता है
यह एक चयनात्मक और विभेदक अगर माध्यम है। इसका उपयोग माइक्रोबियल विज्ञान में एस्कुलिन को हाइड्रोलाइज करने की उनकी क्षमता के आधार पर संवर्धन और कार्बनिक संस्थाओं को अलग करने के लिए किया जाता है। इसके प्रमुख घटकों में एस्कुलिन (एक ग्लाइकोसाइड), पित्त लवण और एक पीएच संकेतक (फेरिक साइट्रेट) शामिल हैं।
यह इस प्रकार काम करता है:
1. चयनात्मकता: अगर में मौजूद पित्त लवण कई ग्राम-पॉजिटिव और कुछ ग्राम-नेगेटिव बैक्टीरिया के विकास को रोकते हैं, जिससे माध्यम विशिष्ट जीवों के लिए चयनात्मक हो जाता है।
2. विभेदक: यह क्षमता वाले कुछ सूक्ष्मजीवों के लिए एक सब्सट्रेट के रूप में कार्य करता है। जब ये जीव एस्कुलिन को तोड़ते हैं, तो यह एस्क्यूलेटिन छोड़ता है, जो माध्यम में फेरिक साइट्रेट के साथ प्रतिक्रिया करता है। यह प्रतिक्रिया हल्के भूरे से मंद अघुलनशील समर्थन में सुधार प्राप्त करती है।
अगर पर रंग परिवर्तन को देखकर, सूक्ष्म जीवविज्ञानी एस्कुलिन हाइड्रोलिसिस के सकारात्मक और नकारात्मक परिणामों के बीच अंतर कर सकते हैं। सकारात्मक परिणाम जीवों के विकास के चारों ओर गहरे भूरे से काले रंग को दिखाते हैं, जो एस्क्यूलेटिन के उत्पादन का संकेत देता है। नकारात्मक परिणाम कोई रंग परिवर्तन नहीं दिखाते हैं, जो एस्क्यूलिन हाइड्रोलिसिस की अनुपस्थिति का सुझाव देता है।
यह एंटरोकोकस फ़ेकैलिस और कुछ स्ट्रेप्टोकोकस प्रजातियों जैसे विशिष्ट जीवों की पहचान करने में सक्षम बनाता है, जो एस्कुलिन हाइड्रोलिसिस के लिए सकारात्मक हैं और एस्कुलिन एगर पर विशिष्ट रंग परिवर्तन उत्पन्न करते हैं।
प्राकृतिक स्रोत क्या है?
इसका प्राकृतिक स्रोत हॉर्स चेस्टनट पेड़ (एस्कुलस हिप्पोकैस्टेनम) की छाल है। यह एक ग्लाइकोसाइड यौगिक है जिसे इस पेड़ की छाल या बीज से हटाया जा सकता है। यह अन्य पौधों की प्रजातियों जैसे कॉमन बकआई (एस्कुलस ग्लबरा) और जापानी हॉर्स चेस्टनट (एस्कुलस टर्बिनाटा) में भी कम मात्रा में पाया जाता है।

ये पौधे यूरोप, उत्तरी अमेरिका और एशिया के क्षेत्रों के मूल निवासी हैं। हॉर्स चेस्टनट का पेड़ इसका प्राथमिक प्राकृतिक स्रोत है।
कौन से जीव एस्कुलिन पॉजिटिव हैं?
इसका उपयोग आमतौर पर माइक्रोबियल विज्ञान में विशिष्ट जैविक संस्थाओं के लिए एक विशेष मार्कर के रूप में किया जाता है। इसका उपयोग विशेष रूप से एस्कुलिन को हाइड्रोलाइज करने के लिए सूक्ष्मजीवों की क्षमता का परीक्षण करने के लिए किया जाता है, जो गहरे भूरे से काले अवक्षेप का उत्पादन करता है। कुछ जीव जिन्हें एस्क्यूलिन हाइड्रोलिसिस के लिए सकारात्मक माना जाता है उनमें शामिल हैं:
1. एंटरोकोकस फ़ेकैलिस: यह जीवाणु, जो आम तौर पर पाचन अंगों और मूत्र क्षेत्र में पाया जाता है, एस्कुलिन हाइड्रोलिसिस प्रदर्शित करने के लिए जाना जाता है।
2. स्ट्रेप्टोकोकस बोविस: इस स्ट्रेप्टोकोकस प्रजाति के कुछ उपभेद एस्कुलिन को हाइड्रोलाइज कर सकते हैं।

3. एरोकोकस विरिडन्स: यह बैक्टीरिया, जो अक्सर मानव श्वसन पथ और त्वचा में पाया जाता है, एस्कुलिन हाइड्रोलिसिस के लिए सकारात्मक है।
यह ध्यान रखना महत्वपूर्ण है कि एस्कुलिन हाइड्रोलिसिस इन प्राणियों को पहचानने के लिए उपयोग किया जाने वाला केवल एक ट्रेडमार्क है, और वैध विशिष्ट प्रमाण के लिए आगे के परीक्षण की उम्मीद की जा सकती है।
एस्कुलिन का उपयोग क्या है?
इसके कुछ उद्देश्य और अनुप्रयोग हैं। इसे आम तौर पर इसके शमन, कैंसर रोकथाम एजेंट और वासोकोनस्ट्रिक्टिव गुणों के लिए पारंपरिक चिकित्सा में उपयोग किया जाता है। इसके कुछ विशिष्ट उपयोगों में शामिल हैं:
1. त्वचा का स्वास्थ्य: त्वचा की उपस्थिति पर काम करने, जलन को कम करने और यूवी क्षति से बचाने की क्षमता के कारण इसका उपयोग अक्सर त्वचा देखभाल उत्पादों में किया जाता है। इसे कई बार आंखों के नीचे की सूजन और काले घेरों को कम करने पर ध्यान केंद्रित करने वाली क्रीम, साल्व और सीरम में पाया जाता है।
2. परिसंचरण समर्थन: ऐसा माना जाता है कि यह रक्त वाहिकाओं को मजबूत करता है और रक्त परिसंचरण में सुधार करता है, जिससे यह वैरिकाज़ नसों और बवासीर जैसी स्थितियों के उपचार में उपयोगी होता है।

3. सूजन रोधी प्रभाव: इसमें सूजन रोधी गुण पाए गए हैं, जिससे यह सूजन को कम करने और संबंधित लक्षणों से राहत दिलाने में फायदेमंद है।
4. एंटीऑक्सीडेंट गतिविधि: यह एक कैंसर निवारक एजेंट के रूप में काम करता है, शरीर में हानिकारक मुक्त कणों को मारने और कोशिकाओं को ऑक्सीडेटिव दबाव से बचाने में मदद करता है।
5. औषधीय अनुप्रयोग: इसके चिकित्सीय गुणों के लिए पारंपरिक रूप से इसका उपयोग हर्बल चिकित्सा में किया जाता रहा है। यह माना जाता है कि इसमें शांत करने वाला, ज्वरनाशक (बुखार कम करने वाला) और दर्द निवारक (पीड़ा कम करने वाला) प्रभाव होता है। इसका उपयोग आमतौर पर वैरिकाज़ नसों और संबंधित शिरापरक समस्याओं के उपचार के लिए त्वचा क्रीम और बाम में फिक्सिंग के रूप में किया जाता है। इसे विभिन्न सहायक अनुप्रयोगों के लिए पढ़ा गया है, जिसमें एडिमा, शिरापरक अपर्याप्तता और त्वचा संबंधी समस्याओं जैसी स्थितियों के प्रबंधन के संबंध में इसकी वास्तविक सीमा भी शामिल है।

6. अनुसंधान और विकास: इसका उपयोग वैज्ञानिक अनुसंधान में जैव रासायनिक अध्ययन में एक अभिकर्मक के रूप में किया जाता है। इसका उपयोग विभिन्न प्रोटीनों को पहचानने और मात्रा निर्धारित करने के लिए किया जाता है, उदाहरण के लिए, बीटा-ग्लूकोसिडेज़, जो एस्कुलिन को उसके भागों में अलग कर सकता है।
इस बात पर ध्यान देना काफी मायने रखता है कि एस्कुलिन ने आशाजनक प्रभाव दिखाए हैं, आगे की खोज और नैदानिक परीक्षाओं से इसके लाभों और खुराक सुझावों को पूरी तरह से समझने की उम्मीद की जाती है।
एस्कुलिन का उपयोग किन सामग्रियों के साथ किया जा सकता है?
एस्कुलिन, जिसे एस्कुलिन भी कहा जाता है, एक विशिष्ट यौगिक है जो पोनी चेस्टनट पेड़ की छाल में पाया जाता है।एस्कुलिन पाउडरअपने विभिन्न चिकित्सीय गुणों के लिए मूल रूप से घरेलू दवा और सुधारात्मक वस्तुओं में उपयोग किया जाता है। इसका उपयोग अपने सामान को उन्नत करने या स्पष्ट परिभाषाएँ बनाने के लिए विभिन्न सामग्रियों के साथ मिश्रण में किया जा सकता है। यहां कुछ सामान्य सामग्रियां दी गई हैं जिनका उपयोग इसके साथ किया जा सकता है:
1. वाहक तेल: क्रीम, लोशन या मालिश तेल जैसे सामयिक अनुप्रयोग बनाने के लिए शुद्ध एस्कुलिन पाउडर को बादाम तेल, नारियल तेल, या जोजोबा तेल जैसे वाहक तेलों में जोड़ा जा सकता है।

2. हर्बल अर्क: इसे कैमोमाइल, कैलेंडुला, या विच हेज़ल जैसे अन्य घरेलू पौधों के साथ मिलाने से सहक्रियात्मक प्रभाव उत्पन्न हो सकता है और त्वचा या बालों को अतिरिक्त लाभ मिल सकता है।
3. एंटीऑक्सिडेंट: एल-एस्कॉर्बिक एसिड, विटामिन ई, या ग्रीन टी कॉन्संट्रेट जैसे कैंसर रोकथाम एजेंटों को जोड़ने से एस्कुलिन के सेल सुदृढीकरण गुणों को उन्नत किया जा सकता है और त्वचा को अत्यधिक नुकसान से बचाने में मदद मिल सकती है।
4. हयालूरोनिक एसिड: मॉइस्चराइजिंग और त्वचा को कोमल बनाने वाले फॉर्मूलेशन बनाने के लिए इसे हयालूरोनिक एसिड, एक हाइड्रेटिंग घटक के साथ जोड़ा जा सकता है।

5. आवश्यक तेल: लैवेंडर, टी ट्री, या रोज़मेरी तेल जैसे आवश्यक तेलों को शामिल करने से एस्कुलिन युक्त उत्पादों में सुगंध और चिकित्सीय लाभ मिल सकते हैं।
यह ध्यान रखना महत्वपूर्ण है कि सामग्री का विशेष मिश्रण और केंद्रीकरण अपेक्षित उपयोग और विवरण पर निर्भर करेगा। प्योर एस्कुलिन पाउडर पाउडर के साथ उत्पाद तैयार करते समय अनुकूलता, स्थिरता और सुरक्षा सुनिश्चित करने के लिए कॉस्मेटिक केमिस्ट या फॉर्म्युलेटर से परामर्श करना उचित है।
कारखाना
1. शीआन सोनवु के पास पर्याप्त स्टॉक वाली एक फैक्ट्री है। इसके अलावा, शीआन सोनवु के पास उन्नत उपकरणों के साथ एक साफ सुथरा उत्पादन विभाग है। कंपनी के नेतृत्व में, शोधकर्ता ग्राहकों की ज़रूरतों को पूरा करने के लिए नए उत्पाद विकसित करना जारी रखते हैं।
2. शीआन सोनवु के पास उन्नत परीक्षण उपकरण और पेशेवर परीक्षण कर्मी हैं, जो सभी दर्शाते हैं कि शीआन सोनवु का लक्ष्य सटीक और प्रभावी डेटा और अच्छी सेवा प्रदान करना है।


प्रमाणपत्र

पैकेट

रसद अद्यतन

उत्पाद की गुणवत्ता की गारंटी के अलावा, दूसरी सबसे महत्वपूर्ण बात यह है कि ग्राहकों को सामान सुचारू रूप से प्राप्त हो सके। इसलिए, शीआन सोनवु विभिन्न आवश्यकताओं के अनुसार सभी प्रकार के कोरियर की आपूर्ति करता है।

कंपनी की प्रोफ़ाइल
शीआन सोनवू बायोटेक कंपनी लिमिटेड एक पेशेवर चीनी निर्माता और उत्पाद आपूर्तिकर्ता है। इसकी स्थापना 2012 में हुई थी और यह हाई-टेक औद्योगिक क्षेत्र, शीआन शहर, शांक्सी प्रांत, चीन में स्थित है। यह खाद्य योजकों, पौधों, अर्क, एपीएल और स्वास्थ्य देखभाल उत्पादों के अन्य अवयवों के विकास, अनुसंधान और उत्पादन पर पूरा ध्यान देता है। कंपनी पांच प्रकार के कच्चे माल उत्पादों की आपूर्ति करती है: बालों को झड़ने से रोकने वाले पाउडर, नूट्रोपिक, एपीआई, मांसपेशी निर्माण उत्पाद और प्लांट एक्सट्रैक्ट। शीआन सोनवु का ईमानदारी से मानना है कि महान सहयोग का आधार सर्वोत्तम सेवा और अच्छी गुणवत्ता है। तो, आपकी पूछताछ का स्वागत है।
और अगर आप जानना चाहते हैंएस्कुलिन पाउडरकीमत, कृपया XI'an Sonwu Biotech Co., Ltd से संपर्क करें।
ईमेल:sales@sonwu.com
लोकप्रिय टैग: एस्कुलिन पाउडर, चीन, आपूर्तिकर्ता, निर्माता, कारखाना, थोक, खरीदें, कीमत, थोक, शुद्ध, कच्चा, आपूर्ति, बिक्री के लिए















